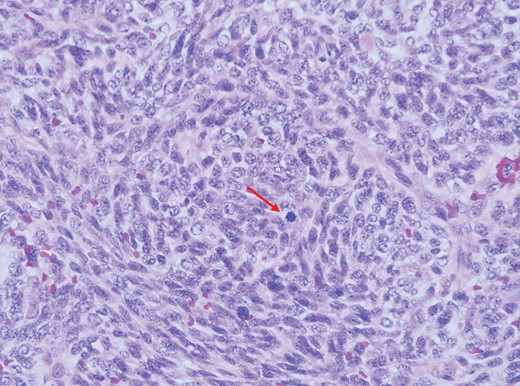
Higher magnification of the malignant spindle cells showing moderate pleomorphism having oval to elongated vesicular to hyperchromatic nuclei, conspicuous nucleoli and minimal eosinophilic cytoplasm. Mitotic figures (arrow) are easily seen (H&E, ×400 magnification).

-
PDF
- Split View
-
Views
-
Cite
Cite
Khairunnisa Che Ghazali, Haniif Ahmad Mazian, Kim Choon Keat, Michael Wong Pak Kai, Mohd Nizam Md Hashim, Andee Dzulkarnaen Zakaria, Wan Zainira Wan Zain, Zaidi Zakaria, Arman Zaharil Mat Saad, Wan Azman Wan Sulaiman, Nurul Atiqah Ahmad Zaidi, Hasnan Jaafar, Collapsed wall: destructive and reconstructive surgery of anterior abdominal wall tumour in a young girl, Journal of Surgical Case Reports, Volume 2019, Issue 2, February 2019, rjy345, https://doi.org/10.1093/jscr/rjy345
Close - Share Icon Share
ABSTRACT
Natural history of abdominal wall soft tissue sarcoma is still poorly understood due to its rarity. In unpublished data of our institution, only seven cases of abdominal wall soft sarcoma with ICD-10 coding of 49.4 were found for past 10 years. We illustrate a case of juvenile fibrosarcoma of anterior abdominal wall. This is a case of young girl with anterior abdominal wall tumour, underwent wide local excision with immediate reconstruction. There are few options of surgical treatment for this case, but which is the best. It is always a challenge in managing young patient with giant abdominal wall defect in view of long term effect namely weakened abdominal wall, pregnancy related issue and risk of herniation and surgical site recurrence as well.
CASE REPORT
This is a 16-year-old girl, who was initially presented with complaint of left iliac fossa pain and discomfort for the past 3 months. She also noticed vague mass at left lower abdomen. Otherwise, she denied any altered bowel habit and no family history of colorectal disease.
On examination, she is a well-built girl. Per abdomen, there is presence of purplish striae, soft, mass palpable at left lower abdomen measuring ~6 × 4 cm2, well demarcated margin, and mild tender on palpation.
Computed tomography (CT) of abdomen showed well defined heterogenous enhancing soft tissue mass at left lower anterior abdominal wall measuring 6.04 × 3.91 × 6.09 cm3. There was presence of area of central necrosis within the lesion with punctate wall calcification. There was no fat component within. The mass has good plane of demarcation with the adjacent external and internal oblique muscle. Poor fat plane between the mass and left rectus abdominis and left transversus abdominis muscle likely due to compression (Fig. 1).

Computed tomography (CT) of abdomen showed well defined heterogenous enhancing soft tissue mass at left lower anterior abdominal wall. The mass has good plane of demarcation with the adjacent external and internal oblique muscle. Poor fat plane between the mass and left rectus abdominis and left transversus abdominis muscle.
With the given clinical examination and CT findings, initial impression was desmoid tumour of abdominal wall. Because of its association with Gardner’s syndrome, colonoscopy was done as part of assessment. Her colonoscopy was unremarkable. She was then undergoing wide local excision and reconstruction of abdominal fascia with pedicle musculocutaneous anterolateral thigh (ALT) fascia lata.
Intraoperatively, lower abdominal incision made, abdominal flap raised up till supraumbilical level, depth until suprafascial layer. Tumour located at left iliac fossa region, well circumscribed, size ~6 × 4 cm2. Tumour was excised with 5 cm margin together with underlying peritoneum. It left ~25 × 20 cm2 defect over anterior abdominal wall, exposing the omentum and bowels (Figs 2–4).

Marking of incision abdominal flap, tumour with 5 cm margin, and donor flap.


Tumour was excised with 5 cm margin together with underlying peritoneum. It left ~25 × 20 cm2 defect over anterior abdominal wall, exposing the omentum and bowels.
Plastic reconstructive team proceed with left pedicled ALT myocutaneous flap with fascia lata (Fig. 5). Vastus lateralis muscle was raised, together with wide fascia lata measuring 26 × 21 cm2 and skin paddle measuring 18 × 5 cm2. Pedicle vessel origin from descending branch of left circumflex femoral artery traced till pivot point ~10 cm below anterior superior iliac spine (ASIS). Then flap was interpolated under subcutaneous skin bridge to cover the fascial defect (Fig. 6).

Marking outline for left anterolateral thigh flap donor site for reconstruction.

Harvested left pedicled anterolateral thigh myocutaneous flap with fascia lata. The flap was interpolated under subcutaneous skin bridge to cover fascial defect.
Patient was monitored in high dependency ward postoperatively. She was kept rest in bed. Drain was in situ and kept for seven days until drain nil. She was advised to wear abdominal corsets. Wound healing as expectant. She was discharge well.
Histopathological examination revealed a fairly circumscribed densely cellular tumour composed of malignant spindle cells arranged mainly in fascicular patterns with focal areas exhibiting herringbone pattern. These malignant spindle cells are non immunoreactive to CD34, SMA and S100 (Figs 7–9).

Higher magnification showing herringbone arrangement (arrow) of the malignant spindle cells (H&E, ×100 magnification).
Higher magnification of the malignant spindle cells showing moderate pleomorphism having oval to elongated vesicular to hyperchromatic nuclei, conspicuous nucleoli and minimal eosinophilic cytoplasm. Mitotic figures (arrow) are easily seen (H&E, ×400 magnification).

The malignant cells are negative for CD34 immunohistochemistry stain. Only blood vessels are highlighted (H&E, ×100 magnification).
DISCUSSION
Soft tissue sarcomas are tumour of mesenchymal origin. It also has various histopathologic subtypes, namely, infantile, juvenile and adult fibrosarcoma. Among adult fibrosarcoma, it is rare and ~1% of adult malignancies in USA [1]. Soft tissue tumour of anterior abdominal wall can give rise to many differentials as well, including sarcomas, desmoid tumour and dermatofibrosarcoma protuberans [2].
Classical case of fibrosarcoma showed characteristic herringbone pattern of malignant fibroblast and it is a diagnosis of exclusion. Infantile fibrosarcoma is synonym with congenital fibrosarcoma, juvenile fibrosarcoma. Histologically, infantile fibrosarcoma is like adult fibrosarcoma but it has a distinctive ETV6-NTRK3 gene fusion which we do not routinely do. Nearly all cases occur in the first year of life [3].
Thus, accurate histologic features are essential. Like in this case, initial impression clinically was desmoid tumour, with supporting evidence points of female gender, child bearing age and location of anterior abdominal wall [3, 4]. However, upon histopathologic examination of resected specimen it showed as juvenile fibrosarcoma.
Given any tissue histology, primary treatment for anterior abdominal wall soft tissue sarcomas are surgery. Wide local resection with adjacent tissue resection (peritoneum, organ, bony structures, etc.) and reconstruction of the wall defect are the choice of treatment [3, 4].
There are many options of technique for abdominal wall reconstruction. It depends on location, defect size and adequacy of tissue coverage. However, options will be limited if defect are large and involve skin and musculofascial layer. Traditionally, choices include component separation, tissue expansion, local flaps or free flaps. For fascial support, options like prosthetic mesh repair or myocutaneous flap or fascia lata can be used [3, 5–7]. In this case, we opted for abdominal wall reconstruction with pedicle ALT flap with tensor fascia lata. ALT fasciocutaneous flap with fascia lata stays as preference of flap for repair of lower abdominal wall as it can provide skin coverage together with fascial support [5, 6]. Besides, the other advantage of ALT flap is its distal portion of blood supply is reliable [8].
Though we understood that primary abdominal wall reconstruction alone might not be adequate in a case of huge defect, and the usage of synthetic mesh reinforcement might be an option, however, this patient is still young, in child bearing age, and possibility of pregnancy in near future. Acellular dermal matrix is one of the options available for coverage of huge defect in abdominal wall reconstruction [9]. In a study done by Garvey et al. [10], he showed that with the usage of acellular dermal matrix for abdominal wall reconstruction, hernia recurrence rate was 11.5% at 3 years and 14.6% at 5 years, and it also can improve long term outcome. Unfortunately, with the high cost of that material, patient could not afford for additional cost.
Even though primary abdominal wall soft tissue sarcoma is rare, aggressive surgical resection is recommended to reduce risk of local recurrence. Pedicled ALT myocutaneous flap with fascia lata reconstruction has shown to be effective and simple for single stage repair for huge anterior lower abdominal wall defect.
Conflict of Interest statement
None declared.